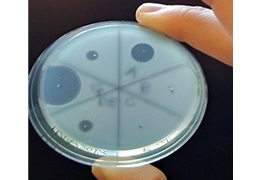
抗菌活性の評価

岩木 宏明 教授
iwaki
【研究室】 環境微生物工学
【研究分野】 環境微生物工学
・ 未知微生物の探索および環境浄化・ものづくりへの応用
・ 環境汚染物質分解菌の遺伝情報解析と機能解析ツールの開発
・ 環境中の微生物を思い通りにコントロールする技術の開発

DNA塩基配列解析
老川 典夫 教授
oikawa
【研究室】 酵素工学
【研究分野】 酵素工学
・ D -アミノ酸の微⽣物、植物、きのこにおける機能の酵素科学的解明
・ D -アミノ酸に着目した機能性⾷品の開発
・ 新規有用酵素及び微生物の探索と産業利用

関西大学×黒酢桶志田コラボ商品D-アミノ酸強化生フルーツ黒酢の開発
片倉 啓雄 教授
katakura
【研究室】 生物化学工学
【研究分野】 生物化学工学
・ 流加培養による乳酸菌に乳酸を作らせない高密度培養
・ 乳酸菌と腸管および食物繊維との相互作用
・ 微生物によるヒアルロン酸、エタノールなどの有用物質生産の高効率化

50 L容固体発酵槽
下家 浩二 教授
shimoke
【研究室】 生命機能工学
【研究分野】 生命機能工学
・ 脳神経系の疾患進行の分子機構の解明とそれら疾患の治療戦略の確立
・ ビズフェノールAによる脳内神経細胞への影響計画
・ エピジェネティック制御による神経細胞への分化機構の解明

神経細胞の顕微鏡画像
住吉 孝明 教授
t-sumiyo
【研究室】 医薬品工学
【研究分野】 医薬品工学
長岡 康夫 教授
ynagaoka
【研究室】 医薬品工学
【研究分野】 医薬品工学
福永 健治 教授
fukunagk
【研究室】 食品栄養化学
【研究分野】 食品化学
細見 亮太 教授
hryotan
【研究室】 食品栄養化学
【研究分野】 食品化学
松村 吉信 教授
ymatsu
【研究室】 微生物制御工学
【研究分野】 微生物制御工学
・ 環境中の有害微生物やバイオフィルムの検出・殺菌・洗浄技術法の開発
・ 新規抗菌システムの開発
・ 微生物による環境汚染物質の浄化に関する研究

タオルに付着しているバクテリア細胞とバクテリア叢解析
山崎 思乃 教授
shino.ya
【研究室】 生物化学工学
【研究分野】 生物化学工学
山中 一也 教授
kazuyay
【研究室】 酵素工学
【研究分野】 酵素工学
・ 微生物ゲノム情報を起点とした新規医薬品シード化合物の探索
・ 微生物由来新規医薬品シード化合物の生合成メカニズムの解析
・ 新規遺伝子工学技術の開発

ゲノム情報に基づいた有用生理活性物質生合成研究
岡野 憲司 准教授
okano.k
【研究室】 環境微生物工学
【研究分野】 環境微生物工学
日下部 りえ 准教授
kusakabe
【研究室】 発生工学
【研究分野】 発生工学
・ 魚類を使った発生工学
・ 骨格筋の形成機構
・ 発生システムの動物種間比較

蛍光タンパク質GFPで筋肉を可視化したメダカ
佐々木 美穂 准教授
sasaki_m
【研究室】 微生物制御工学
【研究分野】 微生物制御工学
安原 裕紀 准教授
yasuhara
【研究室】 細胞工学
【研究分野】 植物生理学、植物細胞工学
・ 高等植物の細胞質分裂装置フラグモプラストの遠心的発達機構
・ 高等植物の細胞核の移動と形態制御の仕組み
・ 高等植物のキネシン様タンパク質の機能解析

フラグモプラストの蛍光顕微鏡写真。微小管を赤、染色体を青に染色している
山口 賀章 准教授
yama
【研究室】 生命機能工学
【研究分野】 生命機能工学
・時差ボケ軽減薬の開発
・概日リズム調整剤の探索
・時計遺伝子分子機構の解明

概日リズムの中枢部位に発現するAVP